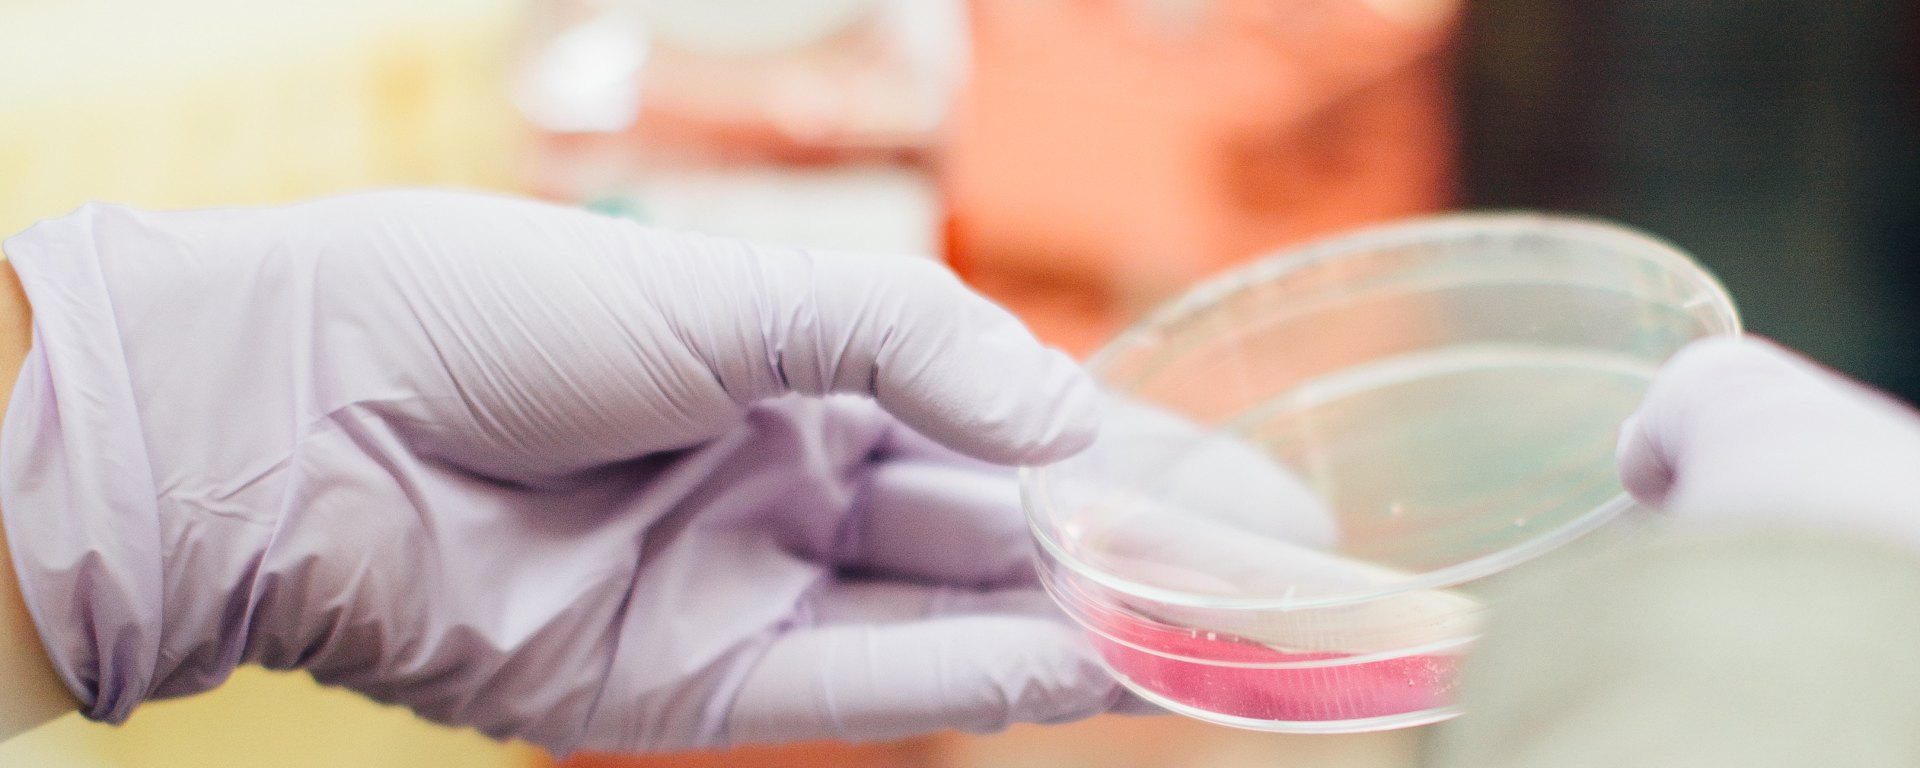

By Fatin Chowdhury ‘19

In an introductory microbiology course, students may learn about bacterial synergy. When bacteria synergistically infect a host through a biofilm, for example, different strains work in conjunction with one another, amplifying their effects. Researchers in Germany, led by Dr. Johannes Arp, recently explored the synergetic tendencies of products from a strain of Pseudomonas bacteria designated as QS1027, which in environmental samples is found located near D. discoideum amoeba, known to consume bacteria. QS1027 produces jessenipeptin, an antimicrobial lipopeptide, and mupirocin, an antibiotic. The researchers found that the two synergistically combatted methicillin resistant S. aureus (MRSA), an infectious bacterium.
Bacteria were isolated from D.discoideum through purification, while amoeba specimens were added to a plaque assay and were observed as they fed on bacteria. The bacteria that were not consumed constituted the QS1027 strain, and were presumed to be inedible to D. discoideum due to the production of compounds that were anti-amoebal. Luria Bertani liquid medium, Carl Roth solid medium, or solid/liquid SM/5 medium was used to propagate the pseudomonas strain. The genomic DNA of the strain was sequenced, and biosynthetic gene clusters (BCGs) were identified. A pks BGC specifically indicated mupirocin as it produced cellular mechanisms, while a nrps BGC indicated lipopeptide production. The deletion of genomic segments and subsequent genomic expression was used to more definitively associate the BCGs and bacterial products. High resolution mass spectrometry was used in conjunction with database references to determine a new molecule, jessenipeptin, and its associated regulatory proteins. Amino acid residues were then found using partial hydrolysis and stable isotope labeling.
The researchers suggested that the bacterial strain underwent adaptation as a result of evolutionary selective pressure experienced when residing near antagonistic amoebae. Their conclusions indicate that the nature and synergistic activities of bacterial products can be further studied to formulate more effective treatments against diseases such as MRSA.
References:
- J. Arp et al., Synergistic activity of cosecreted natural products from amoebae-associated bacteria. Proceedings of the National Academy of Sciences 115, 3758-3763 (2018). doi:10.1073/pnas.1721790115.
- Image retrieved from: https://unsplash.com/photos/tGYrlchfObE